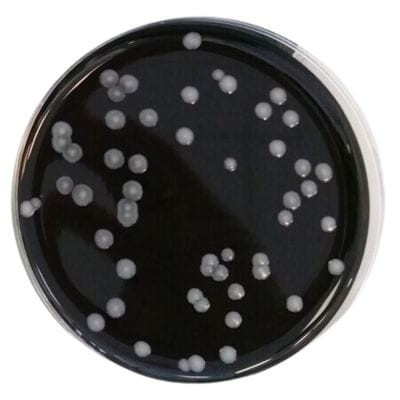
Legionella BCYE with Antibiotics gotowa pożywka na płytkach do izolowania Legionellaceae
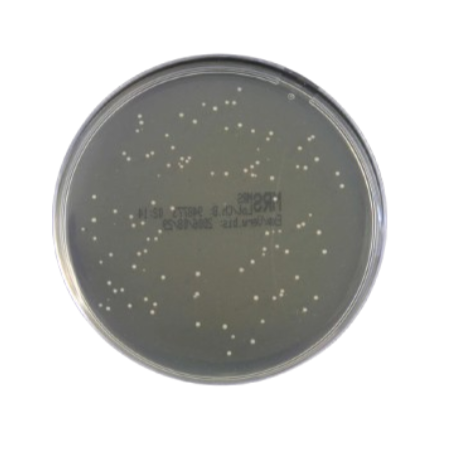
M.R.S. Agar gotowa pożywka na płytkach do oznaczania kwasu mlekowego
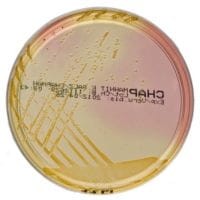
Mannitol Salt Agar gotowa pożywka do oznaczania gronkowców

Znaleziono produktów: 287
 Haemophilus Selective Agar gotowa pożywka na płytkach do izolacji gatunków Haemophilus
Haemophilus Selective Agar gotowa pożywka na płytkach do izolacji gatunków Haemophilus
Podłoża gotowe na płytkach
Producent:
Oxoid
Cena:
31,14 zł
(netto:
28,83 zł
)
zawiera 8% VAT, bez kosztów dostawy
 Hektoen Enteric Agar gotowa pożywka na płytkach do izolacji Shigella i Salmonella spp.
Hektoen Enteric Agar gotowa pożywka na płytkach do izolacji Shigella i Salmonella spp.
Podłoża gotowe na płytkach
Producent:
Oxoid
Cena:
29,86 zł
(netto:
27,65 zł
)
zawiera 8% VAT, bez kosztów dostawy
 Kanamycin Aesculin Azide Selective Medium gotowa pożywka na płytkach do oznaczania enterokoków z próbek żywności
Kanamycin Aesculin Azide Selective Medium gotowa pożywka na płytkach do oznaczania enterokoków z próbek żywności
Podłoża gotowe na płytkach
Producent:
Oxoid
Cena:
38,19 zł
(netto:
31,05 zł
)
zawiera 23% VAT, bez kosztów dostawy
 Legionella BCYE Medium gotowa pożywka do oznaczania bakterii z rodzaju Legionella
Legionella BCYE Medium gotowa pożywka do oznaczania bakterii z rodzaju Legionella
Podłoża gotowe na płytkach
Producent:
Oxoid
Cena:
40,83 zł
(netto:
37,81 zł
)
zawiera 8% VAT, bez kosztów dostawy
Legionella BCYE with Antibiotics gotowa pożywka na płytkach do izolowania Legionellaceae
Legionella BCYE with Antibiotics gotowa pożywka na płytkach do izolowania Legionellaceae
Podłoża gotowe na płytkach
Producent:
Oxoid
Cena:
54,76 zł
(netto:
44,52 zł
)
zawiera 23% VAT, bez kosztów dostawy
 Legionella BCYEa Medium bez cysteiny gotowa pożywka na płytkach
Legionella BCYEa Medium bez cysteiny gotowa pożywka na płytkach
Podłoża gotowe na płytkach
Producent:
Oxoid
Cena:
51,33 zł
(netto:
47,53 zł
)
zawiera 8% VAT, bez kosztów dostawy
 Legionella GVPC Selective Medium gotowa pożywka
Legionella GVPC Selective Medium gotowa pożywka
Podłoża gotowe na płytkach
Producent:
Oxoid
Cena:
44,60 zł
(netto:
36,26 zł
)
zawiera 23% VAT, bez kosztów dostawy
M.R.S. Agar gotowa pożywka na płytkach do oznaczania kwasu mlekowego
M.R.S. Agar gotowa pożywka na płytkach do oznaczania kwasu mlekowego
Podłoża gotowe na płytkach
Producent:
Oxoid
Cena:
25,48 zł
(netto:
23,59 zł
)
zawiera 8% VAT, bez kosztów dostawy
 MacConkey Agar No. 3 gotowa pożywka na płytkach do wykrywania E. coli
MacConkey Agar No. 3 gotowa pożywka na płytkach do wykrywania E. coli
Podłoża gotowe na płytkach
Producent:
Oxoid
Cena:
23,72 zł
(netto:
21,96 zł
)
zawiera 8% VAT, bez kosztów dostawy
Mannitol Salt Agar gotowa pożywka do oznaczania gronkowców
Mannitol Salt Agar gotowa pożywka do oznaczania gronkowców
Podłoża gotowe na płytkach
Producent:
Oxoid
Cena:
21,88 zł
(netto:
20,26 zł
)
zawiera 8% VAT, bez kosztów dostawy
 Maximum Recovery Diluent gotowa pożywka w probówkach
Maximum Recovery Diluent gotowa pożywka w probówkach
Podłoża płynne
Producent:
Oxoid
Cena:
123,48 zł
(netto:
114,33 zł
)
zawiera 8% VAT, bez kosztów dostawy
 Maximum Recovery Diluent pożywka sypka 500g
Maximum Recovery Diluent pożywka sypka 500g
Podłoża sypkie
Producent:
Oxoid
Cena:
71,51 zł
(netto:
58,14 zł
)
zawiera 23% VAT, bez kosztów dostawy
darmowa i wygodna wysyłka
już od 800 zł netto
Najwyższa jakość
produktów potwierdzona certyfikatami
Zakupy 24h na dobę
wygodne i bezpieczne
bezpłatna konsultacja
z ekspertem online


